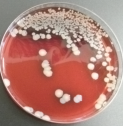
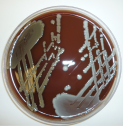

Professor Phil Giffard
Head of Laboratory Science
Qualifications:
PhD, University of Aberdeen (Scotland), 1987; Bachelor of Science (Honours), University of Queensland, 1982.
Approved level of HDR supervision at Charles Darwin University:
Principal Supervisor for PhD
Location:
Darwin - Royal Darwin Hospital campus
Biography:
Phil Giffard conducts research in the field of microbial genetics and genomics, that is relevant to infectious disease.
The focus is upon questions relevant to the population of Northern Territory. Recent projects gave given rise to fundamental findings related to prominent human pathogens. One example is the division of Staphylococcus aureus (Golden Staph) into three species, that are now termed the ‘Staphylococcus aureus complex'.
One of the newly defined species, known as Staphylococcus argenteus (Silver Staph), was first identified in the Northern Territory, but is now known to be globally distributed. Another example is the first complete analysis of Chlamydia trachomatis isolates associated with ocular infection in Australia. This showed that Australian ocular strains are unrelated to ocular strains elsewhere in the world, apart from at a small number of genes that genes, that on the basis of this work, are now thought to confer anatomical tropism.
Phil Giffard has also pioneered the development of a conceptual framework and experimental approach to informing difficult questions related to sexually transmitted infections and child protection in the Northern Territory.
Phil’s expertise is in the development of genetic analysis technologies, and bioinformatics, and more generally in the formulation and application of innovative approaches to address questions of immediate relevance to frontline clinicians in northern Australia.
Research Themes
Phil Giffard is involved in a number of projects addressing the diversity and genetic analysis of the Staphylococcus aureus complex, Streptococcus pyogenes, and Chlamydia trachomatis. He is also involved in continued development of software for deriving highly informative SNP combinations from large-scale databases of genome diversity.
- Giffard, P.M., Andersson P., Wilson J., Buckley C., Lilliebridge R, Harris, T.M., Kleinecke M., O’Grady K.F., Huston W.M., Lambert S.B., Whiley D.M. and Holt D.C. (2018) CtGEM typing: Discrimination of Chlamydia trachomatis ocular and urogenital strains and major evolutionary lineages by high resolution melting analysis of two amplified DNA fragments. PLoS One 13: e0195454.
- Giffard, P.M., Su, J-Y., Andersson, P., & Holt, D.C. (2017) Primary health clinic bathroom/toilet surface swab sampling can indicate community profile of sexually transmitted infections. PeerJ e3487.
- Giffard, P.M., Lilliebridge, R.A., Wilson, J., Murray, G., Phillips, S., Tabrizi, S., Garland, S.M., Martin, L., Singh, G., Tong, S.Y.C., Holt, D.C., & Andersson, P. (2017) Contaminated fingers: a potential cause of Chlamydia trachomatis positive urine specimens. Sex. Transm. Infect. Epub ahead of print.
- Hadfield, J., Harris, S,R., Seth-Smith, H.M.B., Parma, S., Andersson, P, Giffard, P.M., Schachter, J., Moncada, J., Ellison, L., Vaulet, M.L.G., Fermepin, M.R., Radebe, F., Mendoza, S., Ouburg, S., Morré, S.A., Sachse, K., Puolakkainen, M., Korhonene, S.J., Sonnex, C., Wiggins, R., Jalal, H., Brunelli, T., Casprini, P., Pitt, R., Ison, C., Savicheva, A., Shipitsyana, E., Hada, R., Kari, L., Burton, M.J., Mabey, D., Solomon, A.W., Lewis, D., Marsh, P., Unemo, M., Clarke, I.N., Parkhill, J., & Thomson, N.R. (2017) Comprehensive global genome dynamics of Chlamydia trachomatis show ancient diversification followed by contemporary mixing and recent lineage expansion. Genome Res. 27(7):1220-1229.
- Giffard, P. M., Singh, G. and Garland, S. M. (2017) What does Chlamydia trachomatis detection in a urogenital specimen from a young child mean? Sex Transm Infect. 93:236-237.
- Andersson, P., Harris, S.R., Seth Smith, H.M.B., Hadfield, J., O’Neill , C., Cutcliffe , L.T., Douglas, F.P., Asche , L.V., Mathews, J.D., Hutton , S.I., Sarovich, D.S., Tong , S.Y.C., Clarke, I.N., Thomson, N.R. andGiffard, P.M. (2016) Chlamydia trachomatis from Australian Aboriginal people with trachoma are polyphyletic composed of multiple distinctive lineages. Nature Communications, 7:10688.
- Giffard P.M., Brenner N.C., Tabrizi S.N., Garland S.M., Holt D.C., Andersson P., Lilliebridge R.A., Tong S.Y.C., Karimi M., Boylan P., Ryder N., Johns T., and Singh G. (2016) Chlamydia trachomatis genotypes in a cross-sectional study of urogenital samples from remote Northern and Central Australia. BMJ Open. 6(1):e009624.
- Tong S.Y., Schaumburg F., Ellington M.J., Corander J., Pichon B., Leendertz F., Bentley S.D., Parkhill J., Holt D.C., Peters G., Giffard P.M. (2015) Novel staphylococcal species that form part of a Staphylococcus aureus related complex: the non-pigmented S. argenteus and the non-human primate associated S. schweitzeri sp. nov. Int. J. Syst. Evol. Microbiol. 65:15-22.
- Andersson, P, Tong, S.Y.C, Lilliebridge, R.A., Brenner, N., Martin, L.M., Spencer, E., Delima J., Singh G., McCann, F, Hudson, C., Johns, T., Giffard, P.M. (2014) Multi-site direct determination of the potential for environmental contamination of urine samples used for diagnosis of sexually transmitted infections. J. Ped. Infect. Dis. Soc. 3: 189-196.
- Towers, R.J., Carapetis J,R., Currie B.J,, Davies M.R., Walker M.J., Dougan G., Giffard P.M. (2013) Extensive transmission rather than localised diversification. PLoS One. 16;8(9):e73851.